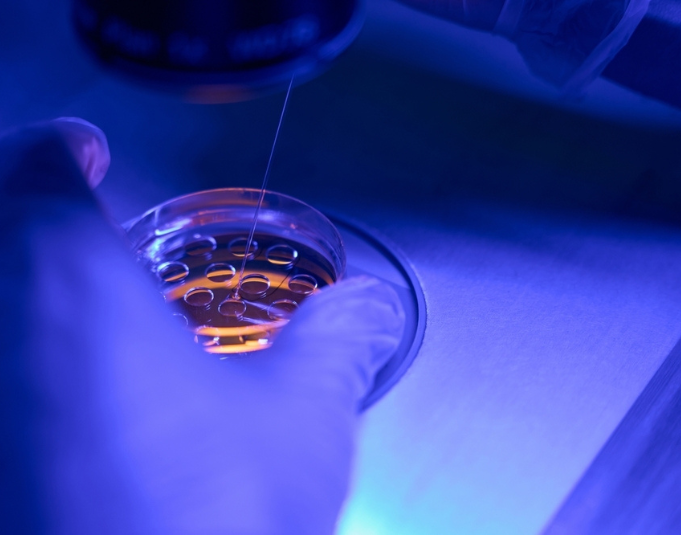
Epilogi emvriwn me time-lapse kai texniti noimosini (1) Επιλογή εμβρύων με time-lapse και τεχνητή νοημοσύνη

Επιλογή εμβρύων με time-lapse και τεχνητή νοημοσύνη
Επιλογή εμβρύων με time-lapse και τεχνητή νοημοσύνη
Η εξωσωματική γονιμοποίηση (IVF) έχει εξελιχθεί σημαντικά, προσφέροντας στα ζευγάρια μεγαλύτερες πιθανότητες επιτυχίας και λιγότερη ταλαιπωρία. Ανάμεσα στις πιο καινοτόμες εφαρμογές συγκαταλέγεται η επιλογή εμβρύων με time-lapse και τεχνητή νοημοσύνη, μια μέθοδος που αξιοποιεί την τεχνολογία για να ενισχύσει την ακρίβεια και την προβλεψιμότητα της θεραπείας. Η προσέγγιση αυτή συνδυάζει τη συνεχή παρακολούθηση της ανάπτυξης των εμβρύων με την υποστήριξη έξυπνων αλγορίθμων, οδηγώντας σε καλύτερα αποτελέσματα και πιο τεκμηριωμένες αποφάσεις.
Πώς λειτουργεί η τεχνολογία time-lapse;
Η τεχνολογία time-lapse καταγράφει σε πραγματικό χρόνο τη διαδικασία της ανάπτυξης των εμβρύων εντός του επωαστή. Ειδικές κάμερες λαμβάνουν εικόνες σε τακτά χρονικά διαστήματα, δημιουργώντας μια συνεχή ακολουθία που απεικονίζει με ακρίβεια την πορεία του εμβρύου.
Μέσω της τεχνολογίας time lapse, ο εμβρυολόγος παρατηρεί:
- Τη χρονική ακρίβεια των κυτταρικών διαιρέσεων.
 - Τη συμμετρία και τη σταθερότητα κατά τη διαδικασία της διαίρεσης.
 - Την κανονικότητα στην εμβρυική συμπεριφορά.
 
Έτσι, κάθε έμβρυο αξιολογείται με βάση ένα ευρύ φάσμα πληροφοριών, οι οποίες συλλέγονται συνεχώς και όχι μόνο σε συγκεκριμένα χρονικά σημεία. Οι παραδοσιακές αξιολογήσεις βασίζονται σε λίγα στιγμιότυπα. Αντίθετα, εδώ παρέχεται από το σύστημα μία δυναμική και πλήρης εικόνα.
Επιλογή εμβρύων με time-lapse: Τεχνητή νοημοσύνη
Η τεχνητή νοημοσύνη μπορεί να αναλύσει αυτόν τον τεράστιο όγκο δεδομένων και να αναγνωρίσει μοτίβα που σχετίζονται με επιτυχή εμφύτευση. Μέσω της μηχανικής μάθησης, οι αλγόριθμοι μαθαίνουν από προηγούμενες περιπτώσεις και προβλέπουν την εξέλιξη του εμβρύου.
Με τη βοήθεια αυτών των αλγορίθμων:
- Εντοπίζονται μικρές αποκλίσεις που δεν ανιχνεύονται από το ανθρώπινο μάτι.
 - Εκτιμώνται οι πιθανότητες επιτυχούς εμφύτευσης για κάθε έμβρυο.
 - Δημιουργούνται προγνωστικές κατατάξεις βάσει στατιστικών μοντέλων.
 
Μέσω της χρήσης συστημάτων τεχνητής νοημοσύνης, ο εμβρυολόγος διαθέτει ένα εργαλείο που ενισχύει τη δική του κρίση και εμπειρία, χωρίς να την υποκαθιστά. Η τεχνολογία λειτουργεί υποστηρικτικά, προσφέροντας αντικειμενικότητα και συνέπεια στην αξιολόγηση.
Συγκριτικά πλεονεκτήματα
Η επιλογή εμβρύων με time-lapse και τεχνητή νοημοσύνη προσφέρει σημαντικά πλεονεκτήματα:
- Αύξηση των ποσοστών επιτυχίας, χάρη στην ακριβέστερη πρόβλεψη του καταλληλότερου εμβρύου.
 - Μείωση των αποτυχημένων κύκλων, που συνεπάγεται λιγότερη οικονομική και ψυχολογική επιβάρυνση.
 - Ασφαλέστερη μονή εμβρυομεταφορά, μειώνοντας τον κίνδυνο πολύδυμων κυήσεων.
 - Τεκμηρίωση της διαδικασίας, με διαφανή παρουσίαση της επιλογής.
 - Εξατομίκευση της θεραπείας, ανάλογα με τα δεδομένα που συγκεντρώνονται για κάθε ζευγάρι.
 
Η δυνατότητα να βλέπει κανείς τη συνεχή πορεία ανάπτυξης κάθε εμβρύου ενισχύει την εμπιστοσύνη των ασθενών προς την ιατρική ομάδα. Στον τομέα της υποβοηθούμενης αναπαραγωγής, πρόκειται για ένα από τα πιο προηγμένα και αξιόπιστα εργαλεία.
Επιλογή εμβρύων με time-lapse και τεχνητή νοημοσύνη: Καθημερινή χρήση της τεχνολογίας
Η τεχνολογία time lapse έχει πλέον ενσωματωθεί σε πολλές μονάδες εξωσωματικής γονιμοποίησης. Οι κάμερες λειτουργούν συνεχώς, καταγράφοντας εικόνες σε τακτά χρονικά διαστήματα. Τα δεδομένα αναλύονται αυτόματα από εξειδικευμένα λογισμικά.
Παρά την εμπειρία, το ανθρώπινο μάτι δεν μπορεί να εντοπίσει εύκολα μικρές λεπτομέρειες σε χιλιάδες εικόνες. Εκεί επεμβαίνει το σύστημα, συμπληρώνοντας την ανθρώπινη κρίση με ακρίβεια και ταχύτητα. Κάθε έμβρυο βαθμολογείται βάσει πρότυπων εμφύτευσης που εξάγονται από τεράστιες βάσεις δεδομένων.
Η διαδικασία γίνεται έτσι πιο στοχευμένη, διαφανής και αξιόπιστη. Η λήψη αποφάσεων βασίζεται σε συνδυασμό εμπειρίας και τεχνολογίας.
Περιορισμοί και προκλήσεις
Παρά τα πολλά πλεονεκτήματα, υπάρχουν και ορισμένοι περιορισμοί. Οι αλγόριθμοι λειτουργούν καλύτερα στο περιβάλλον για το οποίο έχουν εκπαιδευτεί. Επομένως, μπορεί να μην έχουν την ίδια ακρίβεια σε διαφορετικά εργαστήρια.
Ηθικά και δεοντολογικά ζητήματα πρέπει επίσης να εξεταστούν. Η χρήση της τεχνητής νοημοσύνης δεν πρέπει να αφαιρεί τον ανθρώπινο παράγοντα από τη λήψη αποφάσεων. Οι ασθενείς πρέπει να ενημερώνονται με σαφήνεια για το πώς γίνεται η επιλογή.
Το κόστος και η προσβασιμότητα αποτελούν επίσης θέματα συζήτησης. Η χρήση τέτοιων τεχνολογιών πρέπει να γίνει διαθέσιμη σε όσο το δυνατόν περισσότερα ζευγάρια.
Επιλογή εμβρύων με time-lapse και τεχνητή νοημοσύνη: Το μέλλον
Οι ερευνητικές προσπάθειες εστιάζουν στην ενσωμάτωση περισσότερων βιολογικών και γενετικών παραμέτρων στη διαδικασία αξιολόγησης. Η τεχνητή νοημοσύνη μπορεί να χρησιμοποιήσει πληροφορίες από το μεταβολικό προφίλ του εμβρύου και το μικροπεριβάλλον της καλλιέργειας.
Εργαλεία που συνδυάζουν τη χρήση απεικόνισης, γενετικής πληροφορίας και κυτταρικής συμπεριφοράς αναμένεται να ενισχύσουν ακόμη περισσότερο την προγνωστική ακρίβεια. Στον τομέα της υποβοηθούμενης αναπαραγωγής, το επόμενο βήμα είναι η πλήρης εξατομίκευση, με στόχο όχι μόνο την εγκυμοσύνη, αλλά και τη γέννηση ενός υγιούς παιδιού.
Η επιλογή εμβρύων με time-lapse και τεχνητή νοημοσύνη φέρνει επανάσταση στη διαδικασία της εξωσωματικής γονιμοποίησης. Η τεχνολογία time lapse, σε συνδυασμό με τα συστήματα τεχνητής νοημοσύνης, ενισχύει την ακρίβεια, τη διαφάνεια και την επιτυχία.
Το ανθρώπινο μάτι παραμένει θεμελιώδες. Η τεχνολογία όμως προσφέρει έναν πολύτιμο σύμμαχο, βελτιώνοντας την ασφάλεια και την ποιότητα της φροντίδας. Η εξωσωματική γονιμοποίηση δεν είναι πια μόνο μια προσπάθεια. Γίνεται μια τεκμηριωμένη, στοχευμένη και εξατομικευμένη διαδικασία.
Εάν επιθυμείτε να μάθετε περισσότερα για την επιλογή εμβρύων με time-lapse και τεχνητή νοημοσύνη, καθώς και οτιδήποτε μπορεί να σχετίζεται με αυτήν, μπορείτε να επικοινωνήσετε με τους ειδικούς του Gyn Care IVF. Με υπερσύγχρονες εγκαταστάσεις, διακεκριμένους ιατρούς και ένα αληθινό πάθος για την πραγματοποίηση των επιθυμιών σας, η Gyn Care IVF διασφαλίζει μια προσιτή, αλλά παράλληλα ποιοτική εμπειρία.

